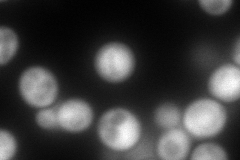
YJR102C
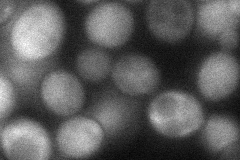
YJR102C
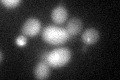
YJR102C
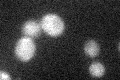
YJR102C
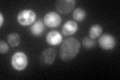
YJR102C

View description
Component of the ESCRT-II complex, which is involved in ubiquitin-dependent sorting of proteins into the endosome
Localization:
Intensity:
Fold change:
Significance:
-
C’ GFP library in SD

below threshold17.5 -
N' NOP1pr-GFP in SD

cytosol112.801 -
N' TEF2pr-mCherry in SD
cytosol237.376 -
N' NATIVEpr-GFP in SD

below threshold16.5428 -
N' TEF2pr-VC and Cyto-VN in SD
cytosol48.047 -
C’ GFP library in SD+DTT
cytosol20.711.18No -
C’ GFP library in SD+H2O2
cytosol18.881.07No -
C’ GFP library in Starvation Media
nucleus182.5110.42No -
C’ GFP library on the background of Pup2-DaMP

below threshold -
C’ GFP library on the background of CCT mutant

below threshold17.9041.02221No
